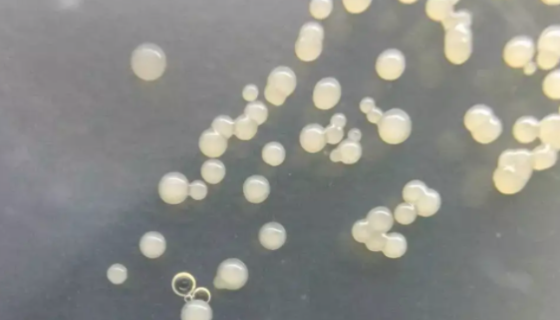
多粘类芽孢杆菌的作用与功效及使用方法！
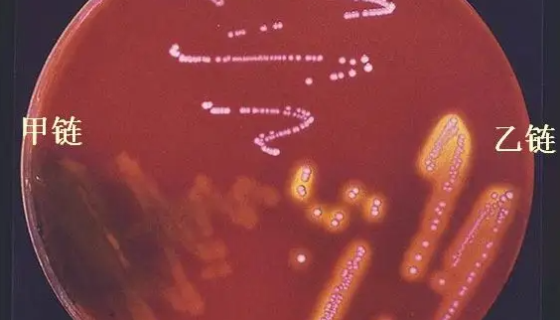
乙型溶血性链球菌的病理分类及检测方法与步骤！

青霉属的培养条件与注意事项及打管说明!
青霉属指的是子囊菌门,不整囊菌纲,曲霉目,发菌科的一属。营腐...
多粘类芽孢杆菌的作用与功效及使用方法!
多粘芽孢杆菌属于细菌,形态特征以椭圆形芽孢使孢囊膨大,芽孢中...

人心肌细胞的培养与使用方法及质量检测!
人心肌细胞分离自心脏组织;心脏是脊椎动物身体中最重要的一个器...

ATCC 19686 副偶然分枝杆菌 百欧博伟生物
副偶然分枝杆菌,在Lowenstein—Jensen培养基内...
乙型溶血性链球菌的病理分类及检测方法与步骤!
乙型溶血性链球菌,是链球菌属中的一种,具有致病性强的特点。可...

小鼠肝细胞的应用及制备方法与操作步骤!
小鼠肝细胞是从对人TGFα进行转基因的小鼠(CD1株,MT4...

原始编号:TA98 鼠伤寒沙门氏菌的注意事项!
鼠伤寒沙门氏菌 TA98的保藏条件与注意事项有哪些?

ATCC 25204 鸡滑液囊支原体 百欧博伟生物
鸡滑液囊支原体的表现症状,如何治疗鸡滑液囊?

嗜热链球菌的性质、用途与生产工艺!
嗜热链球菌被认为是“公认安全性(GRAS)”成分,广泛用于生...